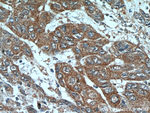
PRL3 Antibody in Immunohistochemistry (Paraffin) (IHC (P))

Search
Proteintech
PRL3 Polyclonal Antibody
{{$productOrderCtrl.translations['antibody.pdp.commerceCard.promotion.promotions']}}
{{$productOrderCtrl.translations['antibody.pdp.commerceCard.promotion.viewpromo']}}
{{$productOrderCtrl.translations['antibody.pdp.commerceCard.promotion.promocode']}}: {{promo.promoCode}} {{promo.promoTitle}} {{promo.promoDescription}}. {{$productOrderCtrl.translations['antibody.pdp.commerceCard.promotion.learnmore']}}
产品信息
15186-1-AP
种属反应
已发表种属
宿主/亚型
分类
类型
抗原
偶联物
形式
浓度
规格
纯化类型
保存液
内含物
保存条件
运输条件
产品详细信息
Immunogen sequence: MARMNRPAP VEVSYKHMRF LITHNPTNAT LSTFIEDLKK YGATTVVRVC EVTYDKTPLE KDGITVVDWP FDDGAPPPGK VVEDWLSLVK AKFCEAPGSC VAVHCVAGLG RKRRGAINSK QLTYLEKYRP KQRLRFKDPH THKTRCCVM (1-148 aa encoded by BC003105 )
靶标信息
The protein encoded by this gene belongs to a small class of prenylated protein tyrosine phosphatases (PTPs). PTPs are cell signaling molecules that play regulatory roles in a variety of cellular processes. This class of PTPs contain a PTP domain and a characteristic C-terminal prenylation motif. Studies of this class of PTPs in mice demonstrated that they were prenylated proteins in vivo, which suggested their association with cell plasma membrane. Overexpression of this gene in mammalian cells was reported to inhibit angiotensin-II induced cell calcium mobilization and promote cell growth. Two alternatively spliced variants exist. PRL-3 expression was found to be up-regulated in human liver carcinoma compared with normal liver. Its expression in colorectal cancers may contribute to the establishment of liver metastasis. In a different study, PRL-3 is found to be expressed in tumor metastasis and vasculature, regardless of the tumor source.
仅用于科研。不用于诊断过程。未经明确授权不得转售。
生物信息学
蛋白别名: HPRL-3; Mutations: 6:OK; phosphatase of regenerating liver 3; potentially prenylated protein tyrosine phosphatase; PRL-3; PRL-R; Protein tyrosine phosphatase type IVA 3; protein tyrosine phosphatase type IVA, member 3; Protein-tyrosine phosphatase 4a3; Protein-tyrosine phosphatase of regenerating liver 3
基因别名: PRL-3; PRL-R; PRL3; PTP4A3
UniProt ID: (Human) O75365
Entrez Gene ID: (Human) 11156